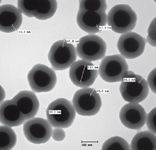

Dual-Use Raman Spectroscopy for Chemical and Biological Agent Identification
The authors discuss the use of a field-deployable Raman instrument for rapid identification of chemical and biological pathogens.
Raman spectroscopy is a powerful tool for chemical substance identification that has gained popularity with first responders, law enforcement personnel, public health and safety agencies, and the military due to the small, portable Raman spectrometers available on the market today. Attempts to use Raman spectroscopy for the direct identification of biological pathogens have been hindered by the complexity of the generated Raman spectra. We report here the use of a sandwich immunoassay containing antibody-modified magnetic beads to capture and concentrate target analytes in solution and surface-enhanced Raman spectroscopy (SERS) tags conjugated with these same antibodies for specific detection. Using this approach, the problems associated with pathogen detection resulting from the spectral complexity and variability of microorganisms are overcome through the use of SERS tags, which provide an intense, easily recognizable, and spectrally consistent Raman signal. The developed assay has a low limit of detection due to the SERS effect, is robust to commonly encountered white powder interferants, and the reagents are stable at room temperature over extended periods of time. This assay is being integrated into a user-friendly interface to be used in conjunction with a Raman instrument for rapid field-deployable chemical and biological identification.
Raman scattering is a powerful tool for molecular analysis and substance identification. Over the past decade, portable Raman spectrometers have become increasingly popular with first responders, law enforcement personnel, public health and safety agencies, and the military. The capability of Raman spectrometers to identify substances inside closed or sealed glass and plastic containers, or from loose samples without the need to physically contact the substance, aids in the identification of contraband narcotics, explosives, and toxic chemicals.
In addition to chemical identification, a need to identify biological threats such as Bacillus anthracis spores or ricin has become paramount to protect both civilian and military personnel. Field-tests such as lateral flow immunoassays (test strips) that use colorimetric or fluorescence detection have become available, but the use of Raman spectroscopy for field identification has so far been limited to the identification of chemicals. We report here the use of Raman spectroscopy for both chemical and biological identification.
Translating Biological Complexity Into Chemical Simplicity
Raman spectroscopy is generally considered a bulk analysis technique, providing chemical identification of the sample's primary composition; it generally does not provide sufficient sensitivity for analyzing trace components or dilute samples. In some cases, this limitation can be overcome by using surface-enhanced Raman spectroscopy (SERS), wherein the intensity of the Raman signal generated by chemicals bound to roughened surfaces of certain metals (such as copper, silver, or gold) is enhanced by 6 to 12 orders of magnitude (1–3).
SERS methods have been used widely to detect and identify certain chemicals based on their unique spectroscopic signatures. For chemical identification, a laser is usually directed at the substance of interest, the scattered light is collected, and a unique "fingerprint" spectrum of the analyzed sample is generated. Attempts have been made to use Raman spectroscopy for identification of biological cells by adsorbing these species onto metallic surfaces and generating a SERS spectrum (4–11). However, even if the material is present in concentrated form, the sample is a complex mixture of cellular components (proteins, lipids, and nucleic acids), and deducing the identity of a threat agent at the species level is a very complex endeavor. The generated SERS spectrum arises from a complicated combination of cellular surface components that must be deconvoluted using chemometrics and a standard spectrum library to produce an unambiguous identification of the target.
By using SERS tags for an indirect biological identification, the biological complexity of a microorganism can be translated into chemical simplicity and Raman can be used for the identification of biological pathogens. We report here the use of a sandwich immunoassay containing antibodies specific for the biological pathogens of interest and Raman reporter molecules for specific identification. The assay uses antibody-modified magnetic beads to capture and concentrate target analytes in solution. Reporter molecules are encapsulated in a composite nanoparticle structure and conjugated with antibodies against the biological species of interest such that the presence of the target biological analyte is determined by the detection of the SERS spectrum from the reporter molecule associated with the attached SERS tag.
The integration of this assay into a user-friendly interface to be used in conjunction with the GE Homeland Protection StreetLab Mobile Raman instrument for rapid field and biological identification will be described.
SERS-Based Sandwich Immunoassay
The direct identification of a biological pathogen from its Raman spectrum is a very complex endeavor due to the multifaceted nature of microorganisms. Using a sandwich immunoassay, the spectrum of a tag specific to the pathogen of interest can be interrogated and the biological pathogen identified. The sample to be identified is collected and transferred into a buffer solution. A portion of this solution is resuspended and transferred into a vial containing the superparamagnetic beads and SERS tags conjugated with antibodies specific to the biological pathogen of interest. This mixture is gently agitated for a specified time interval. A 5-min agitation is usually used, but this agitation time can be increased to improve the sensitivity of the test. During this short agitation step, the antibodies present on the magnetic particles and the SERS tags bind to the antigens present on the surface of the biological analyte to be detected. An SEM of the magnetic capture sandwich obtained by freeze drying a solution sample shows the magnetic particles (Figure 1a) used to capture cells (Figure 1b) and the labeling of these cells with antibody-conjugated SERS tags (Figure 1c).

Figure 1: SEM image of a reacted SERS-based assay showing (a) magnetic capture particles, (b) captured target cells, and (c) SERS tags.
A magnetic field is then employed to concentrate the superparamagnetic particles, SERS tags, and captured biological analyte precisely at the focal point of the Raman laser (Figure 2). The Raman laser interrogates the pellet complex and a signal from the SERS tags is only detected if the SERS tags are pulled into the pellet due to the presence of the pathogen. In the absence of the pathogen of interest, the SERS tags remain in the bulk solution and no SERS signal is detected in the pellet interrogated by the Raman laser.

Figure 2: Schematic of the SERS immunoassay: antibody-functionalized SERS tags interact with B. anthracis, which interacts with antibody-functionalized magnetic beads that are concentrated by a magnetic field and interrogated by a Raman laser.
An important benefit of the magnetic preconcentration is that the magnetic pellet blocks all background SERS signals from the assay solution, thereby eliminating the need for a wash step. Additionally, it is important to note that the characteristic Raman spectrum of the assay pellet is identical to the spectrum collected from the SERS tags alone. There is little to no contribution from the antibodies or cellular material detectable in the Raman spectra of the assay pellet; thus, there is no need for software to deconvolute the SERS spectra from that of the biological material present in the assay.
The unique Raman fingerprint of a given tag allows for the unequivocal identification of the biological pathogen that has been captured. The intensity of the Raman signal increases with the number of captured biological analytes and detected SERS tags. A comparison of the detected signal to a threshold signal determined in the absence of target analyte is used to determine the presence or absence of target analyte. The assay is considered positive or negative if the Raman intensity is higher or lower, respectively, than this threshold value. The threshold value also includes a statistical margin to provide the user with a given level of confidence or false positive rate. The fact that the analyte antibody capture is performed in liquid rather than solid phase provides significant advantages in terms of speed as compared with solid-phase methods.
The specificity of the Escherichia coli test assay was evaluated with 10 E. coli near neighbors using the StreetLab Raman instrument and liquid assay reagents by the Wadsworth Center at the New York State Department of Health (Albany, New York). These bacterial strains included additional toxin-producing E. coli and other enteric illness-causing bacteria. Each organism was grown in liquid media and incubated in conditions appropriate for each organism type for 24 h. Serial dilutions were prepared for each bacterial strain from the broth culture and used for spread plating and subsequent colony forming unit (CFU) counts for concentration determination. Only the most concentrated dilution was tested in duplicate for specificity. No positive results were detected using the 10 E. coli near neighbors, demonstrating that there was no cross-reactivity of the antibodies. The only bacteria to give a positive result were the E. coli O157:H7 that the test was designed to detect.
Limit of Detection With SERS Tags
The silica-encapsulated SERS tags used in this study are composed of a gold core covered with a layer of Raman reporter molecule such as Dipy or BPE protected by a silica coating, as depicted in Figures 3 and 4.

Figure 3: Schematic of a SERS particle.
In contrast to fluorescent labels, SERS tags are resistant to photobleaching, improving the robustness of the assay over fluorescence-based assays and allowing for the use of longer acquisition times to accumulate maximum signal. These tags are coated with a silica shell that provides physical robustness and is an excellent surface for biomolecule attachment, making this type of SERS tag ideal for the biological assays discussed herein.
Figure 4: TEM of individual SERS tags.
SERS tags can also be designed to be immune to specific changes in the detection media, such as pH and temperature. The tags used in this assay are tuned to a 785-nm excitation wavelength, which eliminates much of the fluorescence background noise from field samples.
Unique SERS tags can be prepared by changing the identity of the Raman reporter molecule. Many Raman active chemical reporter molecules are available (Figure 5). These Raman active chemicals can be used to produce SERS tags with distinct spectral signatures, which facilitates multiplex analysis. The inherent Raman line widths, often less than 1 nm, compared to a typical fluorescence signal with line width of 50–100 nm, enable simultaneous interrogation of multiplexed assays using a single excitation source.

Figure 5: Spectra of five unique SERS tags including 4-MP (4-mercaptopyridine), QSH (2-quinolinethiol), BIPY (4,4'-dipyridyl), d-BIPY (4,4'-dipyridyl), and BPE (trans-bis(4-pyridyl)ethylene). Each molecule produces a distinguishable spectrum, thus enabling multiplexing.
The limit of detection of the E. coli test was evaluated by the Wadsworth Center at the New York State Department of Health, with liquid reagents and a compact desktop Raman instrument (StreetLab, GE). Five confirmed strains of E. coli O157 from the Wadsworth Center Culture Collection were used as target bacteria for evaluation of this assay. Assays were run with increasing concentrations of these bacteria using the Raman instrument and liquid E. coli tests. Using these thresholds, the limits of detection obtained when performing tests with liquid reagents were estimated to be 25 E. coli CFU/test for a medium false alarm rate and 50 E. coli CFU/assay when using a lower false alarm rate.
Assay Optimization for Field Use
To increase the stability of the assay in the field and alleviate the need for refrigeration, the liquid reagents were lyophilized. Real-time and accelerated testing at room temperature and 40 °C of these lyophilized reagents are currently in progress. Results obtained thus far show that the reagents used in the E. coli test show no signs of significant loss of activity and confirm that the test has a shelf life of at least one year.
It is of primary importance for a field assay to be robust against commonly found field interferents. Indeed, a vast majority of samples leading to white powder calls are household chemicals, and these should not give a false positive result. In addition, excessive amounts of contaminant may impact the assay performance negatively by physically interfering with the formation of the magnetic pellet; it is also important to ensure that these same chemicals would not interfere with the assay and lead to false negatives and potential health risks. Because the assay is performed in a liquid, the preconcentration of the target of interest in a magnetic pellet reduces the signal from any environmental contaminants. However, it is still important to test for false positives and negatives and the robustness of the SERS assay. The assay was challenged with common household white powders. None of the tested household white powders gave a positive result, showing that these samples would not lead to a false identification.
The assay robustness to false negatives was also tested by the Wadsworth Center at the New York State Department of Health by using the anthrax assay to detect the presence of B. anthracis in the presence of common household items. B. anthracis Ames strain was spiked at approximately 1.4 ×105 spores into solutions containing 0.1 mg/mL of three powder matrices. All assays gave positive results when B. anthracis was present, providing evidence that environmental samples will not interfere with the assay in its current form. Both of these results provide strong evidence that the SERS-based assay is robust enough for field use.
Field Deployment of the SERS-Based Bioassay
The assay is coupled with the GE StreetLab Mobile Raman instrument, which is is designed for handheld, field-deployable identification of both chemicals and biologicals. This ruggedized device is intended to be used by operators who are in personal protective equipment in a chemical or biological "hot-zone." Sample acquisition in the chemical mode occurs in a "point-and-shoot" fashion, where the laser aperture of the instrument is placed directly into or against a clear package containing the sample of interest. This ability to examine substances in various conditions is of particular importance for HazMat analysis of spills or environments that contain shock-sensitive materials in bottles. Additionally, the unit contains an integrated sample vial holder if the user's concept of operations requires a sample to be taken before analysis.

Figure 6: GE cartridge used to perform biological identification on the StreetLab Mobile unit.
The BioSLM cartridge contains premeasured volumes of the SERS and magnetic particle reagents in a stabilized lyophilized form to enable long-term storage at room temperature (Figure 6). This cartridge has been designed for ease of use such that only a minimal number of steps would be needed to complete the biological identification test (Figure 7).

Figure 7: GE StreetLab Mobile biological assay workflow.
After collecting a powdered sample using the supplied swab, the swab is inserted into buffer contained in the cartridge and mixed. A portion of the liquid sample is then moved into contact with the stabilized and lyophilized reagents, and the solution is mixed for a short amount of time, typically a few minutes.
During the mixing step, the capture particles, as well as the SERS tags, bind to the target of interest, thereby creating a capture particle–target–SERS tag sandwich. A magnetic field is then applied to the mixture, attracting the magnetic particles, and with them, the threat agents labeled with SERS tags. This concentration step increases the assay sensitivity by increasing the sampling efficiency of the target complexes, which are concentrated at the focal point of a Raman sampling optic.
After the pellet is formed, a Raman spectrum can be obtained. Upon excitation by the laser for 1–5 s, the unique Raman signature of the SERS tag is observed if the target is present. If no threat agent is present, no signal is observed, since the pellet effectively blocks the laser from sampling any unattached SERS tags remaining in solution, allowing the assay to be performed without a time-consuming wash step. The total assay time can be less than 8 min.
Conclusions
Raman spectroscopy has become a powerful tool to aid first responders and hazardous materials response (HazMat) teams in the identification of unknown chemical threats. This capability has been expanded to highly specific and sensitive detection of biological threat agents using SERS-based antibody labeled tags. By combining multiple assay methods in one device, response teams can consolidate their equipment, keep current with fewer instrument operation protocols, and still have access to state-of-the-art technology for the sensitive and selective identification of both chemical and biological threats.
Acknowledgments
The authors would like to thank Orrie Riccobono for the TEM images and Lauraine Denault for the SEM images. The authors would also like to acknowledge the use of data obtained by Dr. Christina Egan and her team from the Wadsworth Center at the New York State Department of Health during the evaluation of the E. coli and anthrax assays on the StreetLab unit.
Marie Lesaicherre and William Scott Sutherland are scientists with GE Homeland Protection, Inc. Michael C. Burrell works out of Clifton Park, New York. Tracy L. Paxon, Amy Linsebigler, and Frank J. Mondello are scientists at GE's Global Research Center in Niskayuna, New York.
References
(1) P.L. Stiles, J.A. Dieringer, N.C. Shah, and R.P. Van Duyne, Annu. Rev. Anal. Chem. 1, 601–626 (2008).
(2) K. Kneipp, M. Moskovits, and H. Kneipp, Surface-Enhanced Raman Scattering: Physics and Applications (Berlin, Springer, 2006).
(3) M.J. Natan, Faraday Discuss. 132, 321–328 (2006).
(4) X. Zhang, M.A. Young, A. Lyandres, and R.P. Van Duyne, J. Am. Chem. Soc. 127(12), 4484–4489 (2005).
(5) S.E. Bell, J.N. Mackle, and N.M. Sirimuthu, Analyst 130, 545–549 (2005).
(6) R.M. Jarvis and R. Goodacre, Chem. Soc. Rev. 37, 931 (2008).
(7) R.M. Jarvis, A. Brooker, and R. Goodacre, Faraday Discuss. 132, 281 (2006).
(8) T.A. Alexander, Spectroscopy 23(7), 36–42 (2008).
(9) W.E. Huang, R.I. Griffiths, I.P. Thompson, M.J. Bailey, and A.S. Whitely, Anal. Chem. 76, 4452 (2004).
(10) S. Shanmukh, L. Jones, J. Driskell, Y. Zhao, R. Dluhy, and R.A. Tripp, Nano Letters 6(11), 2630 (2006).
(11) T.A. Alexander and D.M. Le, Appl. Opt. 46(18), 3878 (2007).

AI-Powered SERS Spectroscopy Breakthrough Boosts Safety of Medicinal Food Products
April 16th 2025A new deep learning-enhanced spectroscopic platform—SERSome—developed by researchers in China and Finland, identifies medicinal and edible homologs (MEHs) with 98% accuracy. This innovation could revolutionize safety and quality control in the growing MEH market.
New Raman Spectroscopy Method Enhances Real-Time Monitoring Across Fermentation Processes
April 15th 2025Researchers at Delft University of Technology have developed a novel method using single compound spectra to enhance the transferability and accuracy of Raman spectroscopy models for real-time fermentation monitoring.
Nanometer-Scale Studies Using Tip Enhanced Raman Spectroscopy
February 8th 2013Volker Deckert, the winner of the 2013 Charles Mann Award, is advancing the use of tip enhanced Raman spectroscopy (TERS) to push the lateral resolution of vibrational spectroscopy well below the Abbe limit, to achieve single-molecule sensitivity. Because the tip can be moved with sub-nanometer precision, structural information with unmatched spatial resolution can be achieved without the need of specific labels.